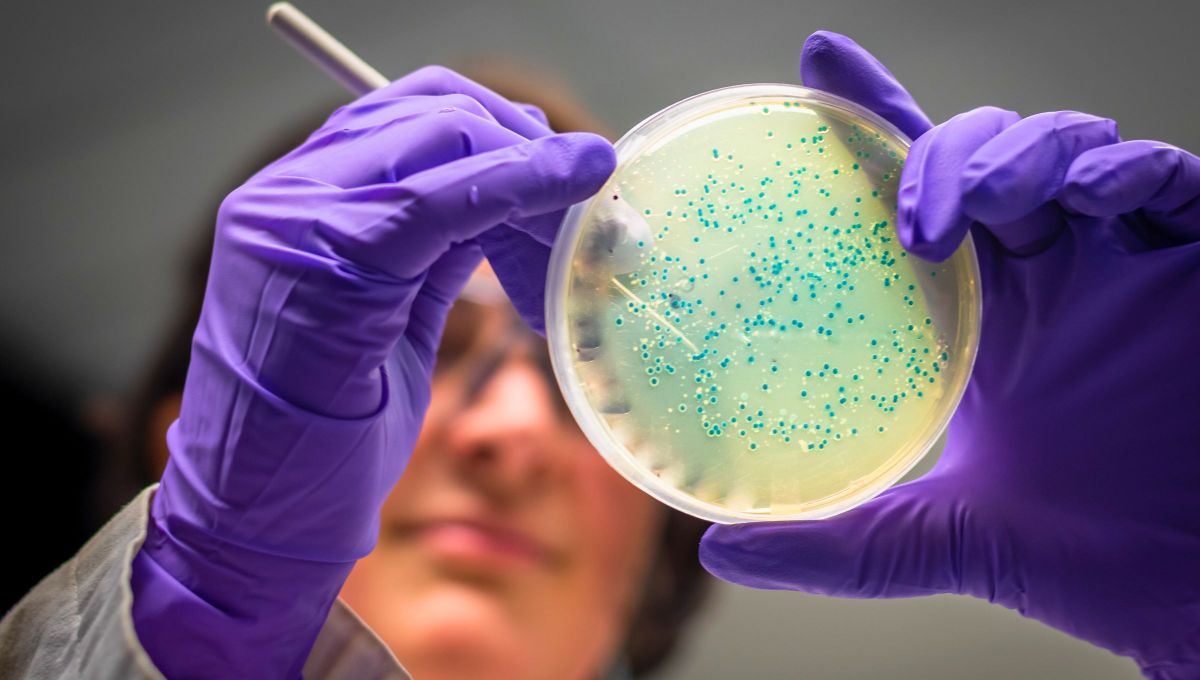
Científicos utilizan bacterias para convertir residuos plásticos comunes en L-DOPA, en uno de los principales fármacos contra la enfermedad de Parkinson. Científicos utilizan bacterias para convertir residuos plásticos comunes en L-DOPA, en uno de los principales fármacos contra la enfermedad de Parkinson.

Cuando hablamos de reciclaje y los efectos de reciclar de una forma diferente, ahora no solo es una cuestión para cuidar el planeta. Gracias a las investigaciones incesantes de la ciencia lograron desarrollar un medicamento para tratar el parkinson de una forma nunca antes vista: apartir de botellas plásticas.
Expertos buscan transformar botellas de plástico en un medicamento para la enfermedad del Parkinson
Un innovador desarrollo científico intenta transformar desechos de plástico, como botellas en compuestos útiles para la enfermedad que afecta el movimiento
Este avance representa un hito histórico en el campo de la revalorización de residuos, que convierte desechos en compuestos de alto valor con un menor impacto ambiental. Pues parece algo poco creíble el hecho de tomar un medicamento a base de plástico y sobre todo que ayuda a tratar una enfermedad que afecta a no menos de 10 millones de personas en el mundo. Pero por el desarrollo que ha logrado la ciencia, hoy es posible.
El desecho de botellas plásticas podría ser un medicamento contra el Parkinson: cómo
Las botellas de plástico forman parte de los residuos más abundantes del planeta. Cada año se producen millones de toneladas de este material, especialmente de polietileno tereftalato, el plástico utilizado para fabricar envases de bebidas. Gran parte termina en vertederos o en el océano, generando un grave problema ambiental. Incluso sin ir más allá, cuando salimos a la calle vemos botellas tiradas en la calle, en veredas, en parques y cuando hay inundaciones por grandes lluvias, se convierten en un gran problema.
Pero ahora, gracias al gran poder y conciencia que genera el reciclaje, las cosas podrían ser diferentes en parte por el gran avance de la ciencia respecto a esto. Investigadores provenientes de Escocia, consiguieron transformar botellas de plástico usadas y desechadas para convertirlas en un medicamento esencial para tratar la enfermedad de Parkinson.
La investigación busca transformar el PET, un tipo de plástico transparente, ligero, fuerte, seguro, irrompible y reciclable, mediante procesos químicos y biotecnológicos para obtener moléculas valiosas. Algunas de estas sustancias pueden utilizarse en la producción de compuestos farmacéuticos que hoy se emplean para tratar enfermedades neurológicas. Según Infobae, lo que buscan es trasformar el plástico de envases comunes en L-DOPA, que es uno de los principales tratamientos para el Parkinson.
Basicamente es como si la bacteria Escherichia coli puede transformar ácido tereftálico (una molécula derivada del plástico PET en botellas y envases) en el principio activo del paracetamol. El procedimiento se parece a la fermentación de la cerveza, que se lleva a cabo a temperatura ambiente y genera emisiones mínimas, en claro contraste con los métodos industriales tradicionales, que dependen del petróleo y emiten gases de efecto invernadero.
Sin embargo, aunque los resultados iniciales son prometedores, los investigadores advierten que todavía quedan varios pasos antes de que este proceso llegue a aplicarse a gran escala. Pero genera una esperanza prometedora.